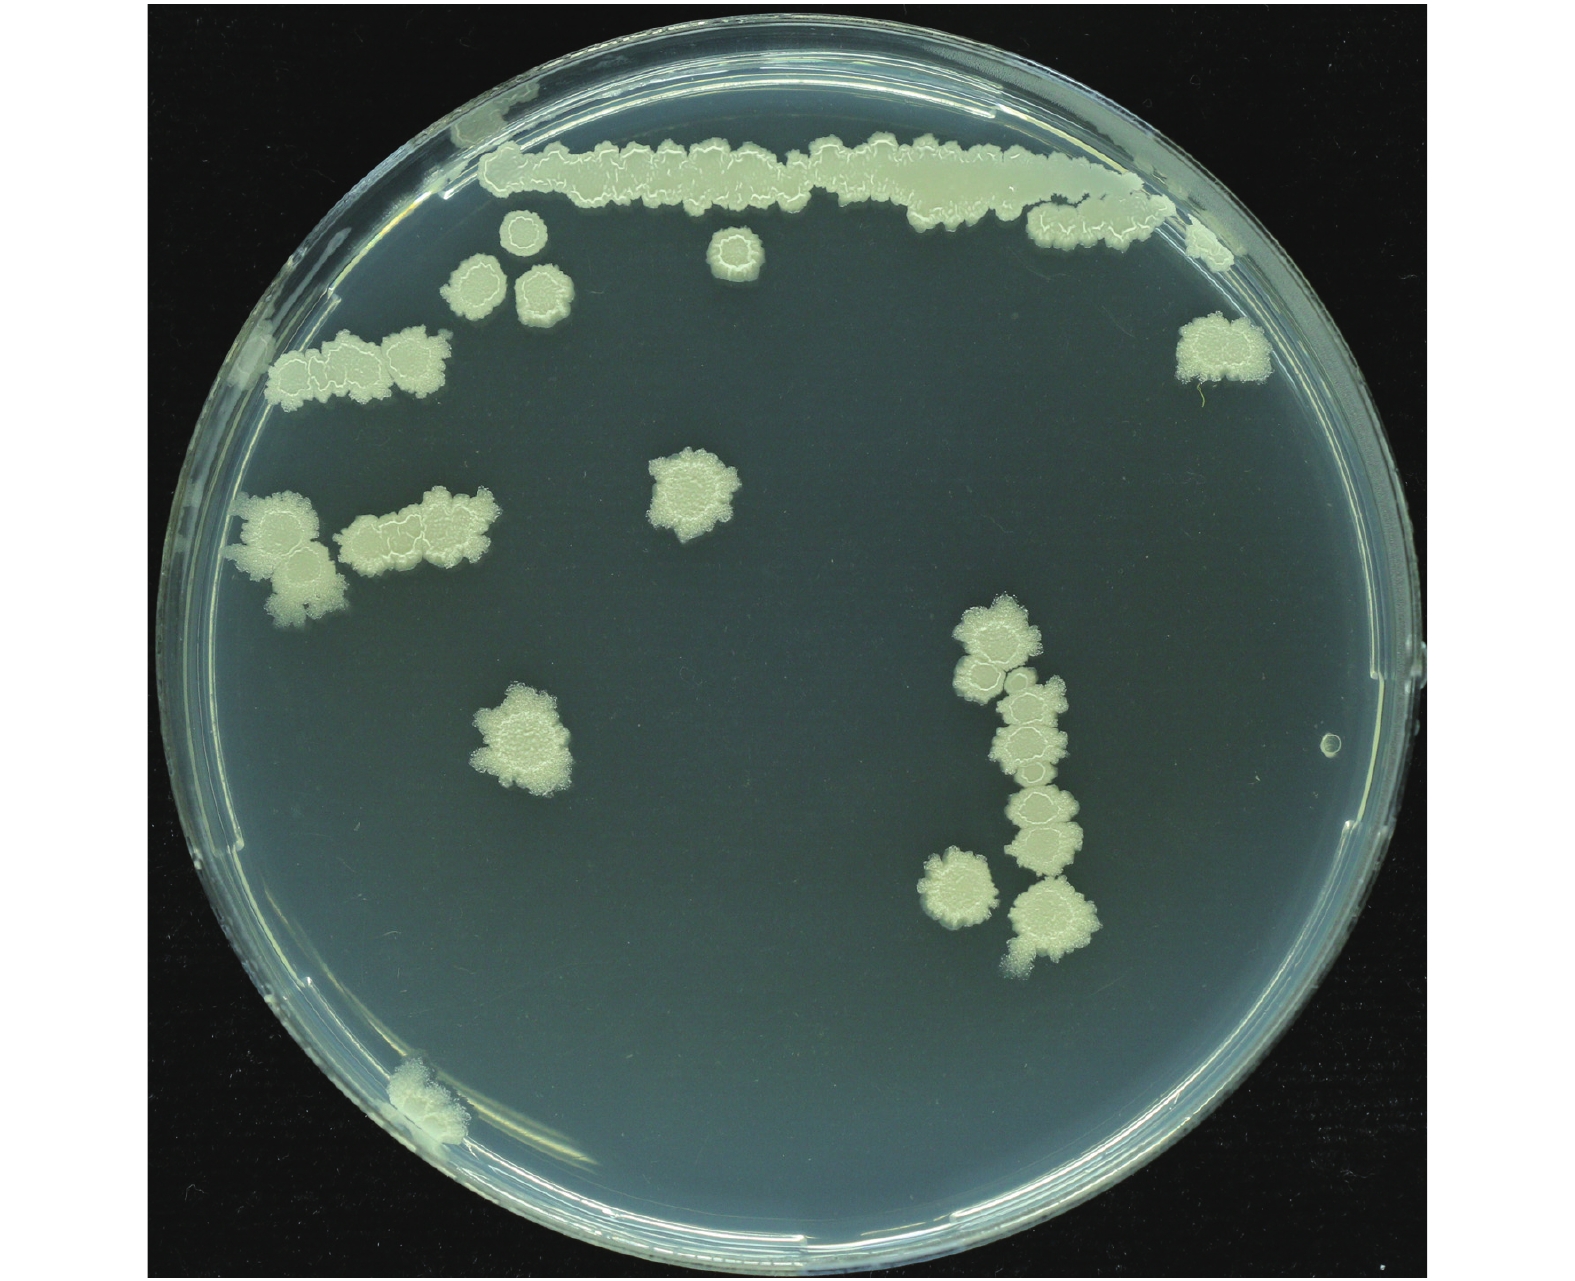
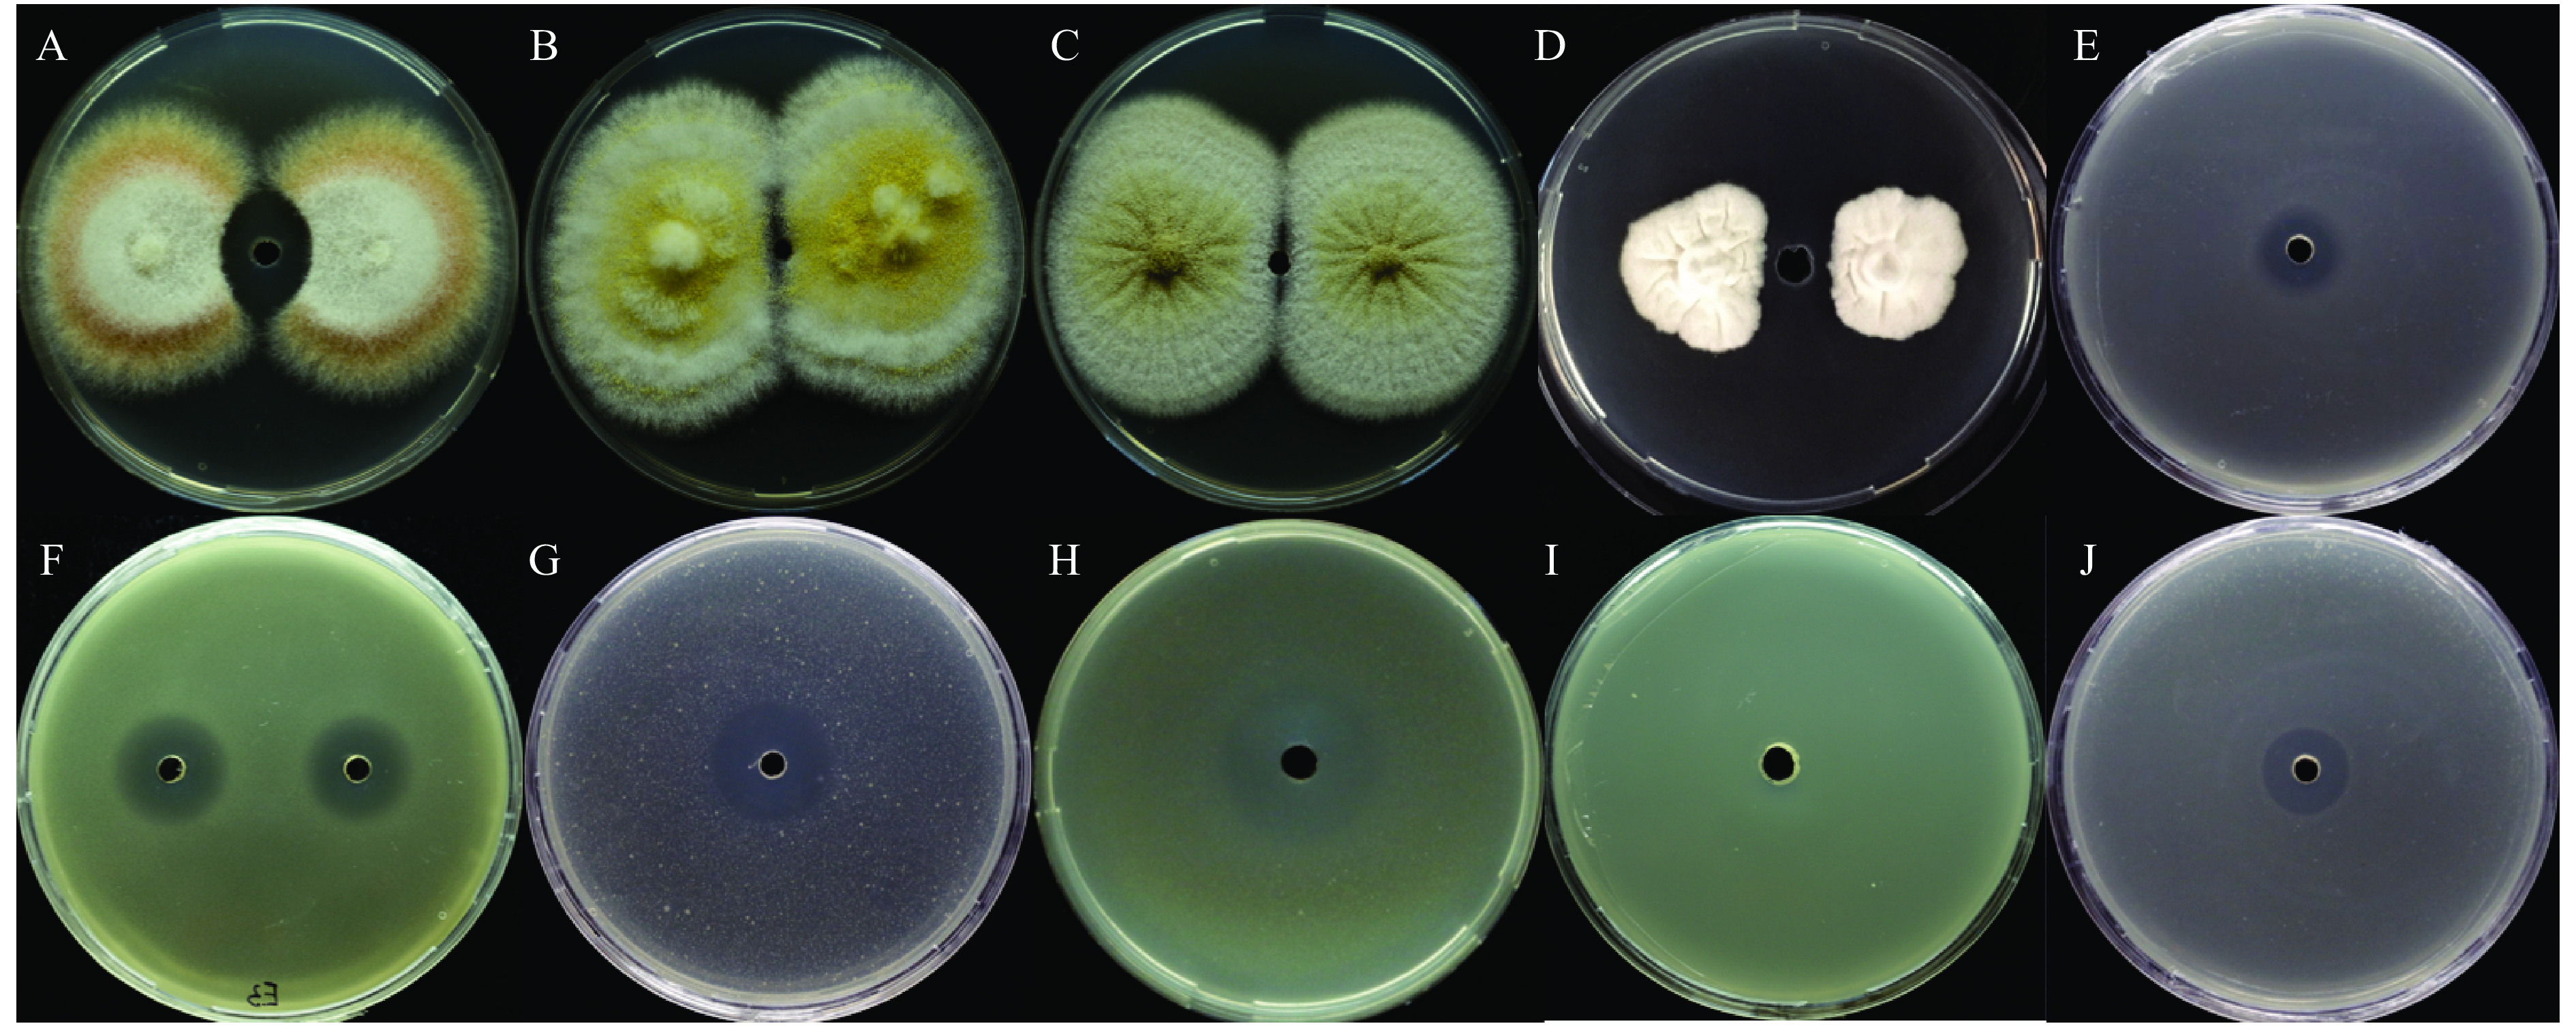

水稻基腐病是由玉米狄克氏菌Dickeya zeae 引起的水稻重要病害之一[1-2]。该病在东南亚一些国家及中国的15个省水稻产区均有报道,近年来其在我国有不断蔓延和加重的趋势[3],是影响我国水稻生产安全的潜在威胁之一。培育抗病品种和喷施化学药剂是目前防控水稻基腐病的主要途径。水稻细菌性基腐病的发生流行快,容易错过最佳防治时间,导致防治效果不佳[4]。同时化学农药的普遍使用和用量增加也带来了一系列问题,包括病原细菌抗药性增强和环境污染等。近年来有关生防菌防治植物病害的报道方兴未艾,生防菌已成为植物病害生物防治的研究热点[5]。绝大多数芽孢杆菌属细菌是非致病菌或益生菌,其广泛栖息在自然环境中。该属约5%~8%的基因合成次生代谢产物,产生几十种拮抗其他病原菌的活性物质,并具有促进植物生长的作用[6],有关芽孢杆菌防治水稻细菌性基腐病的研究鲜见报道。芽孢杆菌分泌的抗菌物质主要有脂肽类化合物[7]、挥发性化合物[8]和抗菌蛋白[9]等。研究表明芽孢杆菌产生的 Fengycin 类和 Iturin 类家族的脂肽类化合物在抑制真菌病害中起着重要作用[10]。Cho 等[11]研究表明,枯草芽胞杆菌 KS03产生的主要抗菌化合物Iturin A 能有效抑制炭疽病菌生长,具有强抗真菌活性。研究表明Fengycins能破坏病原真菌菌丝的超微结构,Fengycins 处理后,真菌细胞膜表面的张力降低,形成微孔,细胞壁遭到破坏[12-13]。Surfactin是一类强大的生物表面活性剂,能诱导植株产生系统抗性[14-15]。Cawoy等[16]研究发现,枯草芽孢杆菌S499产生 Surfactin的能力与其产生诱导抗性物质能力、对灰霉病 Botrytis cinerea 的抵御能力均呈正相关。目前有关水稻基腐病生防菌的研究报道很少,开展对解淀粉芽孢杆菌抗菌物质机理的研究可以为水稻基腐病菌的生物防治提供新的资源,为研制和发掘新型抗菌药物提供理论基础。
本研究从柑橘根际土壤中筛选和鉴定1株拮抗水稻基腐病菌Dickeya zeae EC1生长的Bacillus amyloliquefaciens E3菌株,对其抑菌谱、生防能力、次级代谢产物进行研究,为该菌株的进一步开发应用奠定基础。
1 材料与方法 1.1 材料Dickeya zeae EC1 菌株[17]由华南农业大学群体微生物研究中心张炼辉老师课题组馈赠。黑曲霉Aspergillus niger、黄曲霉Aspergillus flavus、茄病镰刀菌Fusarium solani、雪腐镰刀菌Fusarium nival、洋葱伯克氏菌Burkholderia cenocepacia H111、香蕉基腐病菌Dickeya zeae MS1、柑橘溃疡病菌Xanthomonascitripv. citri菌株jx-6、水稻基腐病菌Dickeya zeae EC1、茄科劳尔氏菌Ralstonia solanacearum GMI1000、大肠埃希菌Escherichia coli DH5α均由群体微生物研究中心实验室保存。
NYD培养基:牛肉膏8 g/L,酵母提取物3 g/L,葡萄糖1 g/L;YPG培养基:酵母提取物10 g/L,蛋白胨20 g/L,葡萄糖20 g/L;YPD培养基:酵母提取物10 g/L,胰蛋白胨20 g/L,葡萄糖20 g/L;YSB培养基:蔗糖20 g/L,酵母提取物20 g/L,牛肉膏15 g/L,MgSO4·7H2O 0.06 g/L,FeSO4·7H2O 0.009 g/L;BYP培养基:牛肉膏5 g/L,蛋白胨10 g/L,酵母提取物5 g/L,葡萄糖10 g/L,NaCl 5 g/L;LB培养基:酵母提取物5 g/L,蛋白胨20 g/L,NaCl 20 g/L,固体培养基则在1 L LB液体培养基的基础上加15 g琼脂粉。
Bio-RAD C1000 Touch PCR仪(美国Bio-rad公司生产),G154DWS立式压力蒸汽灭菌锅[致微(厦门)仪器有限公司],LYNX 6000大型台式冷冻离心机(美国Thermo公司生产),Waters 2998制备型液相色谱(美国Waters世公司生产),Agilent 1260 infinity 高效液相色谱仪(美国Agilent公司生产),色谱柱为Durashell C18柱(10 mm×250 mm×5 μm),多功能酶标仪(BioTek公司生产)。
1.2 方法 1.2.1 水稻基腐病菌拮抗菌株筛选D. zeae EC1拮抗菌的筛选以水稻基腐病菌D. zeae EC1为指示菌,该菌株全长基因组序列已在NCBI GenBank上公开,序列号为NCBI Reference Sequence: NZ_CP006929 (
取湖南省1个柑橘园的根际土壤1 g加到10 mL无菌水中,以28 ℃、200 r/min振荡培养30 min后,用水稀释,稀释梯度为10×、100×和1000×,取100 μL各梯度的稀释液涂布于已经配制好的含有D. zeae EC1的LB固体培养板上。平板风干后放置于28 ℃培养箱内静置培养48 h后,选取有抑菌圈的单菌落划线于新的LB固体培养板上培养至长出单菌落,保存菌种用于进一步的验证。
挑取初筛得到的拮抗菌株单菌落,分别接种于含有200 μL LB液体培养基的96孔培养板中,置于28 ℃摇床振荡培养12 h后,分别取10 μL菌液,加入含有D. zeae EC1的LB固体培养皿中央的直径5 mm的孔内,28 ℃培养箱静置培养24 h,检测是否有抑菌圈,并检测其直径大小。试验共筛选到产生抑菌圈的菌株19株,本研究选取其中抑菌圈最大,直径约20 mm的菌株为研究对象,保存该菌株,并命名为E3。
1.2.2 E3菌株的形态、生理生化特征测定及16S rDNA序列分析将菌株E3划线到LB培养基上,28 ℃条件下培养24 h观察菌落形态。按照标准方法参照MS(i)/C005-C01[18-19],对菌株E3进行生理生化检测。测定的生化指标包括接触酶、苯丙氨酸脱氢酶、氧化酶活性等。
参照文献[20]的方法,以E3菌株基因组DNA为模板,选用引物F27 (5′-AGAGTTTGATCATGGCTCAG-3′)和R1492 (5′-TACGGTTACCTTGTTACGACTT-3′),PCR扩增16S rDNA基因片段。PCR 产物用DNA 凝胶回收纯化试剂盒纯化后,委托北京擎科生物科技有限公司测序。将所得序列通过NCBI数据库进行Blast同源性分析,并采用MEGA5.0软件构建系统发育树。结合菌落菌体形态及其生理生化特征,对E3菌株进行分类鉴定。
根据文献[21]的方法合成2对引物Bsu-man-1F:5′-CAGGCTCACACTTTGTCTTG-3′、Bsu-man-1R:5′-TGAACACAGTCCTGGGTTAG-3′和Bam-man-1F:5′-TCGGTTT CACATCCTTCATC-3′、Bam-man-1R:5′-TTTGTCAGCGTGTCTTCTG-3′。引物由北京擎科生物科技有限公司合成。
1.2.3 E3菌株无菌培养液抑菌活性最优培养基的筛选根据文献[22]的方法,筛选抑菌物质活性最优的培养基。配制了NYD、YPG、YPD、YSB和BPY 5种培养基。将E3接种到含有20 mL培养基的50 mL三角瓶中,28 ℃、200 r/min培养72 h。E3培养液8 000 r/min离心15 min,弃沉淀收集上清液,上清液用0.2 μm的细菌过滤器过滤,吸取10 μL无菌培养液,采用琼脂扩散法测试抑菌活性,每种培养基重复3次,记录抑菌圈直径,用GraphPad绘制图表。
1.2.4 E3菌株无菌培养液对D. zeae EC1侵染水稻种子能力的影响采用纸培法[23]测定E3菌株对D. zeae EC1侵染水稻种子能力的影响。选取健康饱满的水稻种子(‘金刚30’),用双蒸水冲洗4次备用。首先,准备9份水稻种子,每份包含30粒种子;其中8份用于接种D. zeae EC1并分为接种对照组(4份)和接种试验组(4份),每组的4份种子进行相同的接种程序,分别用1.4×106、1.4×105、1.4×104和1.4×103 CFU/mL的D. zeae EC1菌液浸泡,在28 ℃条件下浸泡5 h后,用无菌水冲洗种子3次;另外1份用无菌水处理作为空白对照。将这9份种子分别置于垫有3~4张滤纸(无菌水湿润)的培养皿中,放入恒温培养箱,培养设置参数为:昼夜温度为30 ℃/20 ℃,光照时间为16 h。在保湿培养24 h后,接种试验组的种子喷洒 2 mL 无菌E3培养液,使每一粒种子均匀覆盖培养液,接种对照组和空白对照则采用相同方法用YPG培养基处理。置于培养箱保湿培养每天观察种子萌发情况,4 d 后统计种子萌发情况,计算萌芽率。试验重复3次。
1.2.5 E3菌株分泌的脂肽类物质提取及活性测定采用盐酸沉淀结合丙酮抽提的方法来提取脂肽类物质[24-25]。接种E3单菌落至500 mLYPG液体培养基,在28 ℃、200 r/min条件下,振荡培养3 d。取E3菌株YPG培养液,于8 000 r/min离心15 min后,弃沉淀,取上清液,边搅拌边缓慢加入HCl,调整pH至2.0,4 ℃条件下静置过夜。8 000 r/min离心15 min,倒去上清液,收集沉淀物,用5倍体积的丙酮重悬后,8 000 r/min离心15 min,收集丙酮有机相,沉淀再次用丙酮重悬、离心,重复收集抽提液。混合2次丙酮抽提液,放置于通风橱内风干后,得到脂肽粗提物干粉。用甲醇溶解后,采用0.2 µm的有机滤膜过滤器除菌,得到E3脂肽粗提物溶液,采用Abbkine BCA蛋白定量试剂盒测量质量浓度。采用琼脂扩散法测定其抑菌活性。
1.2.6 E3菌株粗提脂肽类物质的抑菌谱测定参照文献[26],采用平板对峙法测定E3菌株对真菌的抑菌活性。在PDA平板上选取适当的位置放置2块菌饼,在菌饼中间位置用5 mm的打孔器打孔,加10 μL粗提脂肽溶液,质量浓度为5583.5 μg/mL,28 ℃条件下培养3~5 d后观测并记录有无抑菌带产生。细菌抑菌活性测试采用琼脂扩散法,测试粗提脂肽对大肠埃希菌、柑橘溃疡菌、水稻基腐病菌、茄科劳尔氏菌、洋葱伯克氏菌、香蕉基腐病菌的抑菌活性,在含有相应病原菌的LB平板上用5 mm的打孔器打孔,加10 μL粗提脂肽溶液,质量浓度为5583.5 μg/mL,28 ℃条件下培养,观察有无抑菌圈产生。
1.2.7 E3菌株抑菌脂肽类物质的最小抑菌浓度(MIC)测定挑取EC1单菌落于10 mL LB培养基中,28 ℃、200 r/min培养过夜,将培养好的EC1菌液,按照1∶100的体积比接种到新鲜的LB培养基中,混匀后,取100 µL加入到96微孔板中。取100 µL脂肽类溶液(浓度为5583.5 µg/mL)与微板孔的培养基混合均匀,梯度稀释从20到2−12,设置仅200 µL LB培养基和 200 µL 粗提脂肽类物质溶液为阴性对照,接种EC1的LB作为阳性对照,将96孔板置于28 ℃、200 r/min的摇床中培养24 h,用酶标仪测量D600 nm,记录数据并用GraphPad作图。
1.2.8 E3菌株抑菌脂肽类物质的分离纯化脂肽粗提物经琼脂扩散法抗菌活性检测后,采用半制备型高效液相色谱(美国Agilent 1260 Infinity I 液相色谱系统)进行进一步的分离纯化。色谱柱为 C18柱(5 μm×10 mm×250 mm),流动相A:体积分数为0.1%的甲酸水溶液,B:乙腈;等梯度洗脱:V(A)∶V(B) = 20∶80;检测波长:UV 200~400 nm,流速:3 mL/min。每5 min收集1管,共收集8个组分,浓缩后进行抑菌活性测定。
1.2.9 E3菌株抑菌活性物质的鉴定ESI-MS技术是分析脂肽化合物复合体中各组分的相对分子质量及分子结构的有效工具。对于相对分子质量小于1 000的小分子,ESI-MS技术会产生[M+H]+或[M−H]−离子,选择相应的正离子或负离子形式进行检测,就可得到其相对分子质量[27]。本研究采用Thermo UPLC-Q Exactive Focus Orbitrap 液相质谱联用分析仪进行LC-ESI-MS分析,色谱检测条件:色谱柱:Waters HSS T3柱(2.1 mm × 100 mm ×1.8 μm);流速0.3 mL/min,溶剂:流动相A为纯水(加体积分数0.1%的甲酸),流动相B为乙腈,洗脱程序为:0~15 min: 80%~100% B,15~20 min: 100% B。质谱检测条件:离子源:H-ESI, 喷雾电压4.0 kV,鞘气流速:40 psi,辅气流速:10 psi,离子传输管温度:320 ℃;电离模式:Positive;全扫描模式,扫描范围m/z:850~2000。
2 结果与分析 2.1 水稻基腐病菌拮抗菌株的鉴定采用平板抑菌法从湖南柑橘果园根际土壤中分离、筛选拮抗水稻基腐病菌生长的细菌,共筛选到19个菌株,其中,E3菌株抑菌圈直径最大,达20 mm,因此选其作为研究对象。E3菌株在LB平板划线,28 ℃条件下培养2 d后,菌落呈白色不透明、圆形、边缘不整齐,呈锯齿状、表面干燥、有褶皱(图1)。对该菌株进行生理生化分析(表1)发现,E3菌株接触酶、V-P试验和硝酸盐还原反应呈阳性,耐高盐,适宜生长的pH范围为5.7~6.8,可以利用柠檬酸和酪蛋白作为能量来源,并能够降解淀粉、明胶和酪素。
|
图 1 E3菌落形态图 Fig. 1 Colony morphology of strain E3 |
|
|
表 1 水稻基腐病菌拮抗菌 E3菌株的主要生理生化特性 Table 1 The main physiological and biochemical characteristics of Bacillus amyloliquefaciens E3 strain |
对E3菌株的16S rDNA 序列进行相似性分析以及构建菌株亲缘关系发育树,发现该菌株与已公布的 Bacillus amyloliquefacies (GenBank登录号为MN756640.1)亲缘关系最近(图2)。进一步研究发现E3菌株基因组DNA可以扩增解淀粉芽胞杆菌而不是枯草芽孢菌特异的β-甘露聚糖酶基因片段(图3)。根据菌株的菌落表型、生理生化特征,结合16S rDNA 序列分析和特异扩增解淀粉芽胞杆菌β-甘露聚糖酶基因片段结果,确定菌株E3为解淀粉芽胞杆菌Bacillus amyloliquefaciens,并将该菌株命名为B. amyloliquefaciens E3,16S rDNA序列已提交至NCBI,GenBank登录号为MW130122。该菌株于2017年12月7日保藏于中国武汉市武汉大学的中国典型培养物保藏中心(CCTCC),保藏编号为CCTCC No:M 2017768。

|
图 2 依据16S rDNA序列构建的E3菌株系统发育树 Fig. 2 The phylogenetic tree of E3 strain based on 16S rDNA sequence |

|
图 3 β-甘露聚糖酶基因序列特异性扩增电泳结果 Fig. 3 The electrophoresis results of specific amplification of β-mannanase gene sequence M:DS 5000 marker;1:16S rDNA;2:枯草芽孢杆菌β-甘露聚糖酶基因;3:解淀粉芽孢杆菌β-甘露聚糖酶基因 M:DS 5000 marker;1:16S rDNA;2:β-mannanase gene from Bacillus subtilis;3:β-mannanase gene from B. amyloliquefaciens |
芽孢杆菌可以分泌多种抗菌活性物质到胞外拮抗其他微生物的生长,而拮抗物质的表达分泌受外界环境条件的诱导和影响[28]。为确定E3产抑菌物质的最优培养基,通过比较E3无菌培养液抑菌圈的大小,从5种常用培养基中筛选了E3产抑菌活性物质最多的培养基(图4)。从图4可以看出,在营养丰富的YPG培养基中,E3菌株无菌培养液的抑菌圈最大,表明其分泌到胞外的抑菌活性物质最多,故选择YPG培养基培养E3菌株提取抗菌活性物质。

|
图 4 以无细胞上清液的抗菌活性为指标的培养基优化结果 Fig. 4 Results of medium optimization based on the antibacterial activity of cell-free supernatant |
在水稻种子的萌发阶段,水稻基腐病菌D. zeae EC1可以成功侵染,造成种子萌芽腐烂,使种子萌芽率降低,甚至完全不萌发[29]。本研究开展了无菌E3培养液拮抗D. zeae EC1侵染水稻种子的防效试验,以确定E3菌株是否可以降低D. zeae EC1对萌发种子的侵染能力。水稻种子接种不同剂量的D. zeae EC1,同时设置无菌水处理种子为空白对照;每一个浓度处理的试验组种子与无菌E3培养液混匀,而对照组则与等量YPG培养基混匀;种子置于昼夜温度分别为30、20 ℃的培养箱保湿培养4 d后,比较试验组与对照组的萌芽率。由图5可以看出,与空白对照相比,接种了1.4×105 和1.4×104 CFU/mL的 D. zeae EC1对照组种子萌芽率分别降低至20.0%和37.8%,而同时接种了无菌E3培养液对应剂量的试验组种子,萌芽率则大大提高,分别达到63.3%和85.6%,这表明无菌E3培养液可以显著降低D. zeae EC1抑制水稻种子萌发的能力。这些结果表明E3菌株分泌到胞外的抗菌物质可以部分拮抗水稻基腐细菌D. zeae EC1抑制水稻种子萌发的能力。

|
图 5 Bacillus amyloliquefacions E3菌株无菌培养液对Dickeya zeae EC1抑制水稻种子萌芽率的拮抗效果 Fig. 5 Antagonism effect of the sterile culture medium of Bacillus amyloliquefaciens E3 strain on the inhibition of rice seeds germination by Dickeya zeae EC1 “*”、“**”、“***”分别表示0.05、0.01和0.000 1水平的差异显著性(t检验) “*”,“**”,“***” indicate significance differences at the levels of 0.05,0.01 and 0.000 1 respectively (t test) |
采用盐酸沉淀后丙酮抽提的方法,提取E3无菌培养液中的脂肽类物质,用BCA蛋白定量试剂盒测得脂肽粗提物质量浓度为5583.9 mg/mL。对脂肽粗提物进行抑菌活性测定,以无菌培养液为阳性对照,以甲醇作为阴性对照,抑菌效果如图6所示。从图6可以看出,脂肽粗提物和无菌培养液均具有较强的抑菌活性,而对照甲醇没有活性,表明E3的抑菌活性物质主要为脂肽类物质。

|
图 6 Bacillus amyloliquefaciens E3菌株粗提脂肽的抑菌活性 Fig. 6 Antimicrobial activity of crude lipopeptides extracted from Bacillus amyloliquefaciens E3 strain A:甲醇;B:无菌上清液;C:粗提脂肽类物质 A:Methanol;B:Sterile supernatant;C:The crude lipopeptides |
为了测定E3抑菌脂肽粗提物的MIC, 将粗提脂肽(5583.5 μg/mL)以2的倍数进行梯度稀释从20到2−12,与等量的D. zeae EC1混合加入96孔培养板内,振荡共培养24 h后利用酶标仪测定D600 nm。由图7可以看出,E3粗提脂肽质量浓度由1.36 μg/mL升到174.48 μg/mL时,D600 nm与阳性对照(0 μg/mL+EC1)无显著差异,表明其不能抑制D. zeae EC1的生长;而当浓度升高到348.97 μg/mL及以上时,D600 nm与阴性对照(LB培养基)无显著差异,表明其几乎完全抑制了D. zeae EC1的生长。阴性对照LB培养基D600 nm为0,说明LB不存在其他微生物的污染。这些结果表明E3脂肽粗提物可以有效抑制D. zeae EC1的生长,最小抑菌浓度为348.97 μg/mL。

|
图 7 Bacillus amyloliquefaciens E3菌株脂肽粗提物对Dickeya zeae EC1的抑制作用 Fig. 7 Inhibitory effect of crude lipopeptides extracted from Bacillus amyloliquefaciens E3 strain against Dickeya zeae EC1 “*”、“**”分别表示0.05和0.000 1水平的差异显著性(t检验) “*”,“**” indicate significance differences at the levels of 0.05 and 0.000 1 respectively (t test) |
采用平板对峙法检测E3菌株对真菌的拮抗作用,采用琼脂扩散法检测E3菌株对细菌的拮抗作用。结果(图8)发现,除了抑制水稻基腐病菌D. zeae EC1的生长外,E3脂肽粗提物也拮抗茄病镰刀菌、香蕉基腐病菌、柑橘溃疡病菌、茄科劳尔氏菌和大肠埃希菌的生长,但是对黑曲霉、黄曲霉、雪腐镰刀菌和洋葱伯克氏菌的生长则没有任何抑制作用。由此可见,B. amyloliquefaciens E3粗提脂肽类物质对多种植物细菌和真菌都有一定的抑制作用,具有广谱的抑菌活性。
|
图 8 Bacillus amyloliquefaciens E3菌株的抗真菌谱 Fig. 8 The antimicrobial spectrum of strain Bacillus amyloliquefaciens E3 strain A:茄病镰刀菌Fusarium solani;B:黄曲霉Aspergillus flavus;C:黑曲霉Aspergillus niger;D:雪腐镰刀菌Fusarium nival;E:大肠埃希菌Escherichia coli;F:柑橘溃疡菌Xanthomonas citri pv. citri;G:水稻基腐病菌 Dickeya zeae EC1;H:茄科劳尔氏菌Ralstonia solanacearum;I:洋葱伯克氏菌Burkholderia cenocepacia;J:香蕉基腐病菌Dickeya zeae MS1 |
为了进一步分离鉴定 E3分泌的拮抗D. zeae EC1的主要抑菌活性物质的化学成分,将E3脂肽粗提物用高效液相色谱柱C18柱进行分离, 按时间收集各馏分,每5 min收集1管,共得到8个馏分,采用琼脂扩散法分别检测这8个馏分的抑菌活性。根据抑菌圈的大小来判断,发现馏分2 (5~10 min)和馏分5 (20~25 min)具有抗菌活性,而且抑菌活性成分主要集中在馏分5 (图9)。将馏分2和馏分5旋转蒸发浓缩,进行下一步的LC-MS分析。

|
图 9 HPLC 纯化分离抑菌物质各馏分活性检测图 Fig. 9 Determination of antibacterial activity of each fraction isolated and purified by HPLC 1~8:HPLC收集的馏分;9:脂肽粗提物;10:甲醇 1−8: Fractions collected by HPLC; 9: Crude lipopeptides; 10: Methanol |
收集具有抗菌活性的馏分2和馏分5,用LC-ESI-MS鉴定各馏分的主要化学成分(图10)。馏分2中检测到主要的分子离子峰[M+H]+ 为1435.77、1449.79、1463.80、1477.82和1491.83,相对分子质量相差14,恰好是一个亚甲基—CH2的相对分子质量。通过对比抗菌脂肽类化合物的理论相对分子质量,可以推测该组物质属于Fengycin类化合物(图10B)。在分析活性馏分5的质谱图时发现,其主要的分子离子峰[M+H]+ 为994.64、1008.66、1022.67、1036.69和1050.70,与脂肽物质Surfactin的相对分子质量相吻合,据此推断该组物质为Surfactin类化合物或者其同系物(图10D);另外馏分5还发现了[M+H]+ 为1058.67、1072.69、1086.70,它们属于 C15~C17 的 Iturin B类化合物的质子加合峰。脂肽类抗生素质谱峰的分析参考陈华等[27]和 Vater等[30]研究。

|
图 10 馏分2和馏分5 的HPLC-ESI-MS分析 Fig. 10 HPLC-ESI-MS analysis of fraction 2 and 5 |
根据以上质谱分析结果判断,馏分2的主要抑菌物质包括Fengycin A和Fengycin B,馏分5的主要抑菌物质包括Surfactin和Iturin类化合物。由此可以推断,B. amyloliquefaciens E3产生的主要抑菌物质为Fengycin、Surfactin和Iturin 3种脂肽类抗生素,且馏分5鉴定的Surfactin可能起主要的抑菌活性。至于是否还有其他的抑菌活性物质,还需进一步的验证分析。
3 讨论与结论众多研究表明,许多根际土壤分离的微生物是根际促生菌(Plant growth promoting rhizobacteria,PGPR),这类微生物在适应环境生长过程中分泌多种具有生物活性的次生代谢物,具有抗菌、竞争性抑制病原菌生长或诱导植物产生系统抗性等作用,有效拮抗病原菌的侵染,并能促进植物生长,可以作为生防菌防治植物病害,因而受到植物病理学家的广泛重视[31-32]。近年来,有关分离及鉴定根际促生菌并将其用于防治植物病害的研究日趋广泛和深入,逐渐成为生物防治领域的有效途径[33]。芽孢杆菌属Bacillus细菌是一种典型的根际促生菌,抗逆性强,能产生环状脂肽、聚酮类、挥发性化合物和抗菌肽等多种抑菌活性物质,具有很好的生防应用潜力[34]。解淀粉芽孢杆菌B. amyloliquefaciens FZB42是研究最深入的根际促生菌模式菌株,具有广谱抗性,已经在农业上广泛用于防治番茄、棉花、草莓和马铃薯等多种植物病害[35]。众多研究表明芽孢杆菌分泌的环状脂肽Surfactin、Fengycin 和 Iturin不仅拮抗镰刀菌Fusarium、立枯丝核菌Rhizoctonia solani、海枣曲霉菌Aspergillus phoenicis、禾草离蠕孢菌Bipolaris sorokiniana等多种植物病原真菌生长,还具有诱导植物产生抗性的功能。Chowdhury等[36]研究表明,解淀粉芽孢杆菌 FZB42能够产生Surfactin、Fengycin 和 Bacillomycin D,抑制立枯丝核菌的生长,在生菜遇到病原菌侵染时还能够介导植株产生防御性反应;向亚萍等[37]从解淀粉芽孢杆菌B. amyloliquefaciens B1619菌株发酵物中分离出3种脂肽类抗生素,其中,Bacillomycin L 和 Fengycin是抑制番茄枯萎病菌Fusarium oxysporum f.sp. lycopersici生长的主要物质。Surfactin可以抑制丁香假单胞菌Pseudomonas syringae和多种黄单胞菌Xanthomonas等病原菌的生长[38]。Zeriouh等[39]发现2株枯草芽孢杆菌B. subtilis UMAF6614 和UMAF6639 可以拮抗黄单胞菌Xanthomonas campestris pv. cucurbitae 和果胶杆菌 Pectobacterium carotovorum subsp.生长,主要抑菌活性成分为Iturin。Cao等[40]分离得到贝莱斯芽孢杆菌B. velezensis Y6 菌株,并发现该菌株分泌的Fengycin和Surfactin是抑制细菌性青枯菌Ralstonia solanacearum生长的主要物质,而Iturin则是抑制尖孢镰刀菌Fusarium oxysporum孢子萌发的主要物质。这些研究进展表明脂肽类物质在生物防治病原细菌方面有巨大的潜力。
玉米狄克氏细菌Dickeya zeae,异名为菊花欧文氏菌Erwinia chrysanthemi pv. zeae,除感染水稻引起水稻基腐病外,还侵染玉米、马铃薯、香蕉等多种双子叶和单子叶植物,引起茎腐病和软腐病等多种细菌性病害,给农业生产造成严重的经济损失。Hadizadeh 等[41]发现黏性沙雷氏菌Serratia plymuthica A3菌株可以拮抗Dickeya solani生长,可减轻马铃薯在低温贮藏过程中软腐病发病率,以及田间栽培过程中病原菌从母薯向子薯的传播。Chen 等[42]报道解淀粉芽孢杆菌B. amyloliquefaciens D2WM菌株能够抑制引起软腐病的D. chrysanthemi生长,并发现多酮类化合物 Macrolactin为其主要抑菌活性物质。Li等[43]筛选并鉴定了对Dickeya zeae 有拮抗作用的3个菌株Pseudomonas fluorescens SC3、P. parafulva SC11 和 B. velezensis 3-10,室内接种试验表明3个菌株均具有作为生防菌的潜力。本研究从柑橘根际土壤中筛选到1株拮抗水稻基腐菌的B. amyloliquefaciens菌株,鉴定并命名为E3。研究发现该菌株培养液可以有效降低水稻基腐病菌对水稻种子的侵染能力,其分泌的Surfactin、Fengycin和Iturin 3种脂肽类物质为主要抑菌活性成分。本研究结果进一步丰富了解淀粉芽孢菌拮抗植物病原细菌的资源库,也为防治水稻基腐病寻找安全、环保新型生物农药提供了新的依据。
| [1] |
冯成玉. 水稻细菌性基腐病发生情况与研究进展[J]. 中国稻米, 2009(4): 21-23. DOI:10.3969/j.issn.1006-8082.2009.04.007 (  0) 0) |
| [2] |
刘琼光, 张庆, 魏楚丹. 水稻细菌性基腐病研究进展[J]. 中国农业科学, 2013, 46(14): 2923-2931. DOI:10.3864/j.issn.0578-1752.2013.14.008 (  0) 0) |
| [3] |
PU X M, ZHOU J N, LIN B R, et al. First report of bacterial foot rot of rice caused by a Dickeya zeae in China
[J]. Plant Disease, 2012, 96(12): 1818. (  0) 0) |
| [4] |
张蝶. 浙江省水稻细菌性基腐病发生因素及化学防治研究[D]. 金华: 浙江师范大学, 2016.
(  0) 0) |
| [5] |
SANSINENEA E, VACA J, ELENA ROJAS N, et al. A wide spectrum of antibacterial activity of secondary metabolites from Bacillus amyloliquefaciens ELI149
[J]. Bioscience Journal, 2020, 36(1): 235-244. (  0) 0) |
| [6] |
BEN ABDALLAH D, TOUNSI S, GHARSALLAH H, et al. Lipopeptides from Bacillus amyloliquefaciens strain 32a as promising biocontrol compounds against the plant pathogen Agrobacterium tumefaciens
[J]. Environmental Science and Pollution Research, 2018, 25(36): 36518-36529. DOI:10.1007/s11356-018-3570-1 (  0) 0) |
| [7] |
STEIN T. Bacillus subtilis antibiotics: Structures, syntheses and specific functions
[J]. Molecular Microbiology, 2005, 56(4): 845-857. DOI:10.1111/j.1365-2958.2005.04587.x (  0) 0) |
| [8] |
WU L M, WU H J, CHEN L N, et al. Difficidin and bacilysin from Bacillus amyloliquefaciens FZB42 have antibacterial activity against Xanthomonas oryzae rice pathogens[J]. Scientific Reports, 2015, 5(1). doi: http://doi.org/10.1038/srep12975.
(  0) 0) |
| [9] |
LIU Y F, CHEN Z Y, NG T B, et al. Bacisubin, an antifungal protein with ribonuclease and hemagglutinating activities from Bacillus subtilis strain B-916
[J]. Peptides, 2007, 28(3): 553-559. DOI:10.1016/j.peptides.2006.10.009 (  0) 0) |
| [10] |
TAO Y, BIE X M, LV F X, et al. Antifungal activity and mechanism of fengycin in the presence and absence of commercial surfactin against Rhizopus stolonifer
[J]. Journal of Microbiology, 2011, 49(1): 146-150. DOI:10.1007/s12275-011-0171-9 (  0) 0) |
| [11] |
CHO S J, LEE S K, CHA B J, et al. Detection and characterization of the Gloeosporium gloeosporioides growth inhibitory compound iturin A from Bacillus subtilis strain KS03
[J]. FEMS Microbiology Letters, 2003, 223(1): 47-51. DOI:10.1016/S0378-1097(03)00329-X (  0) 0) |
| [12] |
CAO H Y, JIAO Y, YIN N, et al. Analysis of the activity and biological control efficacy of the Bacillus subtilis strain Bs-1 against Meloidogyne incognita
[J]. Crop Protection, 2019, 122: 125-135. DOI:10.1016/j.cropro.2019.04.021 (  0) 0) |
| [13] |
ZHAO P, QUAN C, WANG Y, et al. Bacillus amyloliquefaciens Q-426 as a potential biocontrol agent against Fusarium oxysporum f. sp spinaciae
[J]. Journal of Basic Microbiology, 2014, 54(5): 448-456. DOI:10.1002/jobm.201200414 (  0) 0) |
| [14] |
ARGUELLES-ARIAS A, ONGENA M, HALIMI B, et al. Bacillus amyloliquefaciens GA1 as a source of potent antibiotics and other secondary metabolites for biocontrol of plant pathogens
[J]. Microbial Cell Factories, 2009, 8: 63. DOI:10.1186/1475-2859-8-63 (  0) 0) |
| [15] |
ONGENA M, JACQUES P. Bacillus lipopeptides: Versatile weapons for plant disease biocontrol
[J]. Trends in Microbiology, 2008, 16(3): 115-125. DOI:10.1016/j.tim.2007.12.009 (  0) 0) |
| [16] |
CAWOY H, MARIUTTO M, HENRY G, et al. Plant defense stimulation by natural isolates of Bacillus depends on efficient surfactin production
[J]. Molecular Plant-Microbe Interactions, 2014, 27(2): 87-100. DOI:10.1094/MPMI-09-13-0262-R (  0) 0) |
| [17] |
ZHOU J, CHENG Y, LV M, et al. The complete genome sequence of Dickeya zeae EC1 reveals substantial divergence from other Dickeya strains and species
[J]. BMC Genomics, 2015, 16(1): 571. DOI:10.1186/s12864-015-1545-x (  0) 0) |
| [18] |
东秀珠, 蔡妙英. 常见细菌系统鉴定手册[M]. 北京: 科学出版社, 2001: 267-294.
(  0) 0) |
| [19] |
布坎南, 等. 伯杰细菌鉴定手册[M]. 北京: 科学出版社, 1984: 729-758.
(  0) 0) |
| [20] |
REDBURN A C, PATEL B K. Phylogenetic analysis of Desulfotomaculum thermobenzoicum using polymerase chain reaction-amplified 16S rRNA-specific DNA
[J]. FEMS Microbiology Letters, 1993, 113(1): 81-86. DOI:10.1111/j.1574-6968.1993.tb06492.x (  0) 0) |
| [21] |
刘勇, 毛爱军, 李辉, 等. 枯草芽孢杆菌群β-甘露聚糖酶基因克隆及同源性分析
[J]. 基因组学与应用生物学, 2009, 28(5): 845-850. DOI:10.3969/gab.028.000845 (  0) 0) |
| [22] |
韩玉竹, 邓钊, 张宝, 等. 解淀粉芽孢杆菌H15产抗菌肽的发酵条件优化和提取方法比较研究[J]. 食品科学, 2015, 36(15): 135-141. DOI:10.7506/spkx1002-6630-201515025 (  0) 0) |
| [23] |
张睿佳, 胡杰, 陆建忠, 等. 不同成熟度对水稻种子萌发的影响[J]. 上海农业科技, 2017(5): 62-63. DOI:10.3969/j.issn.1001-0106.2017.05.029 (  0) 0) |
| [24] |
LI S B, XU S R, ZHANG R N, et al. The antibiosis action and rice-induced resistance, mediated by a lipopeptide from Bacillus amyloliquefaciens B014, in controlling rice disease caused by Xanthomonas oryzae pv. oryzae
[J]. Journal of Microbiology and Biotechnology, 2016, 26(4): 748-756. DOI:10.4014/jmb.1510.10072 (  0) 0) |
| [25] |
朱弘元, 康健, 范昕, 等. 解淀粉芽孢杆菌B15产脂肽的分离鉴定及抑菌机理[J]. 江苏农业科学, 2016, 44(5): 186-189. (  0) 0) |
| [26] |
张玉胜, 谭亚男. 油菜核盘菌拮抗菌的筛选及鉴定[J]. 生命科学仪器, 2009, 7(8): 27-28. (  0) 0) |
| [27] |
陈华, 王丽, 袁成凌, 等. 高效液相色谱-电喷雾质谱法分离和鉴别枯草芽孢杆菌产生的脂肽类化合物[J]. 色谱, 2008(3): 343-347. DOI:10.3321/j.issn:1000-8713.2008.03.016 (  0) 0) |
| [28] |
CHEN M C, WANG J P, ZHU Y J, et al. Antibacterial activity against Ralstonia solanacearum of the lipopeptides secreted from the Bacillus amyloliquefaciens strain FJAT-2349
[J]. Journal of General and Applied Microbiology, 2019, 126(5): 1519-1529. DOI:10.1111/jam.14213 (  0) 0) |
| [29] |
周海亮. 水稻细菌性基腐病病原学及检测技术的研究[D]. 武汉: 华中农业大学, 2012.
(  0) 0) |
| [30] |
VATER J, GAO X, HITZEROTH G, et al. "Whole cell"--matrix-assisted laser desorption ionization-time of flight-mass spectrometry, an emerging technique for efficient screening of biocombinatorial libraries of natural compounds-present state of research[J]. Combinatorial Chemistry& High Throughput Screening, 2003, 6(6): 557-567. (  0) 0) |
| [31] |
AERON A, KHARE E, JHA C K, et al. Revisiting the plant growth-promoting rhizobacteria: Lessons from the past and objectives for the future[J]. Archives of Microbiology, 2020, 202(4): 665-676. DOI:10.1007/s00203-019-01779-w (  0) 0) |
| [32] |
GOUDA S, KERRY R G, DAS G, et al. Revitalization of plant growth promoting rhizobacteria for sustainable development in agriculture[J]. Research in Microbiology, 2018, 206: 131-140. DOI:10.1016/j.micres.2017.08.016 (  0) 0) |
| [33] |
KHAYALETHU N, LESIBA K L, MOLEMI E R, et al. The mode of action of bacillus species against Fusarium graminearum, tools for investigation, and future prospects[J]. Toxins, 2019, 11(10). doi: http://doi.org/10.3390/toxins11100606.
(  0) 0) |
| [34] |
严婉荣, 肖敏, 陈圆, 等. 解淀粉芽孢杆菌抗菌脂肽研究进展[J]. 北方园艺, 2018(7): 162-167. (  0) 0) |
| [35] |
FAN B, WANG C, SONG X, et al. Bacillus velezensis FZB42 in 2018: The gram-positive model strain for plant growth promotion and biocontrol
[J]. Frontiers in Microbiology, 2018, 9: 2491. DOI:10.3389/fmicb.2018.02491 (  0) 0) |
| [36] |
CHOWDHURY S P, UHL J, GROSCH R, et al. Cyclic lipopeptides of Bacillus amyloliquefaciens subsp. plantarum colonizing the lettuce rhizosphere enhance plant defense responses toward the bottom rot pathogen Rhizoctonia solani
[J]. Molecular Plant-Microbe Interactions, 2015, 28(9): 984-995. DOI:10.1094/MPMI-03-15-0066-R (  0) 0) |
| [37] |
向亚萍, 周华飞, 刘永锋, 等. 解淀粉芽孢杆菌B1619脂肽类抗生素的分离鉴定及其对番茄枯萎病菌的抑制作用[J]. 中国农业科学, 2016, 49(15): 2935-2944. DOI:10.3864/j.issn.0578-1752.2016.15.008 (  0) 0) |
| [38] |
FIRA D, DIMKIC I, BERIC T, et al. Biological control of plant pathogens byBacillus species
[J]. Biotechnology Journal, 2018, 285: 44-55. DOI:10.1016/j.jbiotec.2018.07.044 (  0) 0) |
| [39] |
ZERIOUH H, ROMERO D, GARCIA-GUTIERREZ L, et al. The iturin-like lipopeptides are essential components in the biological control arsenal of Bacillus subtilis against bacterial diseases of cucurbits
[J]. Molecular Plant-Microbe Interactions, 2011, 24(12): 1540-1552. DOI:10.1094/MPMI-06-11-0162 (  0) 0) |
| [40] |
CAO Y, PI H L, CHANDRANGSU P, et al. Antagonism of two plant-growth promoting Bacillus velezensis isolates against Ralstonia solanacearum and Fusarium oxysporum[J]. Scientific Reports, 2018, 8(1). doi: http://doi.org/10.1038/S41598-018-22782-Z.
(  0) 0) |
| [41] |
HADIZADEH I, PEIVASTEGAN B, HANNUKKALA A, et al. Biological control of potato soft rot caused by Dickeya solani and the survival of bacterial antagonists under cold storage conditions
[J]. Plant Pathology, 2019, 68(2): 297-311. DOI:10.1111/ppa.12956 (  0) 0) |
| [42] |
CHEN J, LIU T, WEI M, et al. Macrolactin a is the key antibacterial substance of Bacillus amyloliquefaciens D2WM against the pathogen Dickeya chrysanthemi
[J]. European Journal of Plant Pathology, 2019, 155(2): 393-404. DOI:10.1007/s10658-019-01774-3 (  0) 0) |
| [43] |
LI J, HU M, XUE Y, et al. Screening, identification and efficacy evaluation of antagonistic bacteria for biocontrol of soft rot disease caused by Dickeya zeae[J]. Microorganisms, 2020, 8(6975). doi: 10.3390/microorganisms8050697.
(  0) 0) |
 2021, Vol. 42
2021, Vol. 42


